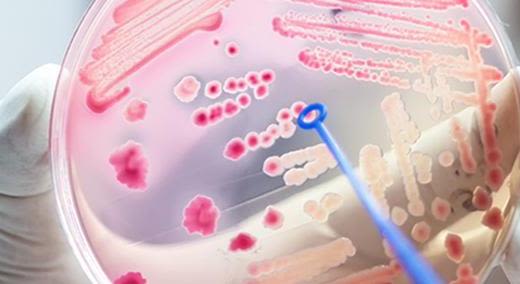
Silicone Elastomers

-
Ingredient Name:
Propionic Acid
-
Chemical Name:
Propionic acid
-
CAS Number:
79-09-4
-
Functions:
API Intermediate,
Intermediate,
Preservative,
Preservative
-
Synonyms:
Carboxyethane, Ethanecarboxylic Acid, Ethylformic Acid, Metacetonic Acid, Methylacetic Acid, Propanoic Acid, Pseudoacetic Acid
MultiTech Preservative A is a water-soluble organic acid serving a range of applications. MultiTech Preservative A is used as a versatile preservative in food or feed industry. For bakery products it preserves as a proprionate. In animal feed applications, propionic acid preserves compound feed, grain or corn while reducing mold or yeast. In silage applications it improves fermentation. It also serves as a synthetic building block to produce pharmaceuticals, crop protection agents and solvents, as well as thermoplastics.